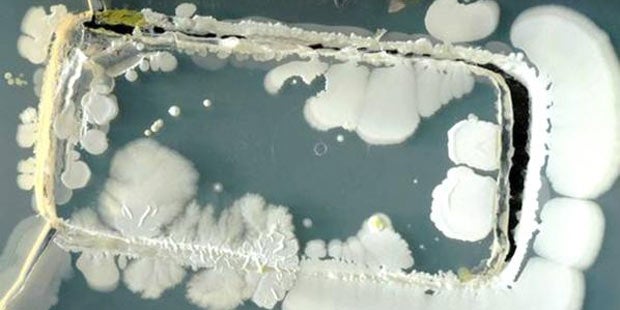
So ekelig sind unsere Smartphones
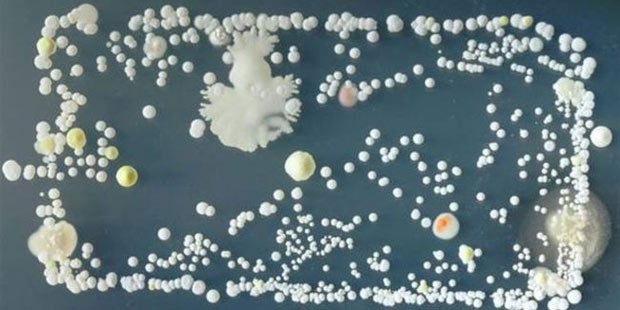
So ekelig sind unsere Smartphones

Gefundene Keime können sogar zu schweren Krankheiten führen.
Viele haben es bereits vermutet, doch nun haben wir es schwarz auf weiß: Smartphones sind wahre Bakterien- und Keimsammler. Das ist das Ergebnis einer aktuellen Studie aus Großbritannien. Laut den Forschern der University of Surrey ist vor allem der sorglose Umgang mit den multimedialen Alleskönnern die Hauptursache für die starke Keimbelastung. Denn die Nutzer verwenden ihre Smartphones fast immer und vor allem überall. Auch beim Essen oder auf der Toilette. Da ist es keine allzu große Überraschung, dass die Geräte viele Bakterien und Keime förmlich anziehen.
So sah das Ergebnis nach nur drei Tagen aus.
Hort für Mikroorganismen
Wie verschmutzt unsere Handys tatsächlich sind, haben die Forscher in beeindruckender Weise dargestellt. Sie haben Smartphones in Petrischalen gedrückt. Im Anschluss daran haben sie die Kulturen dann drei Tage lang (bei Körpertemperatur) in Ruhe gelassen. Am Ende des Versuchs kam ein ekeliges Gewächs aus Bakterien und Mikroorganismen zum Vorschein. Dabei handelte es sich Großteils zwar um harmlose Erreger. Es waren aber auch Fäkalbakterien und ansteckende Keime mit dabei. Letztere können sogar zu lebensbedrohlichen Erkrankungen wie Lungenentzündungen führen.
Einige der gefunden Erreger waren sogar richtig gefährlich.
Das raten die Experten
Tipp des Studienleiters und Bakterienexperten Dr. Somon Park: Vor der Handy-Nutzung immer die Hände waschen und das Smartphone regelmäßig säubern – auch mit Desinfektionsmitteln (ein Mal pro Woche).
>>>Nachlesen: Studie: Handys erhöhen Hirntumor Risiko

















